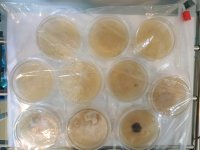
agar2.jpg
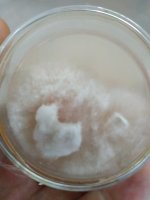
pan-myc2.jpg

intosamadhi
Rising Star
Does anyone have any handy advice for working with spore prints made from wild mushrooms (ie non-sterile)? I am struggling to get the spores that I have collected to sporulate. I've gone through dozens of agar plates and all of them end up horribly contaminated with little to no signs of mycelium.
I've tried plain water agar, as I saw a video about using this as a way to get a small amount of mycelium to form without having bacteria overtake it too quickly, but that didn't work at all.
I've tried dropping spores on soaked and sterilized cardboard but nothing here either.
I'm using PDA for my plates. I sterilize everything with a pressure cooker and work in a still airbox trying to keep things as sterile as possible (which amounts to dousing everything with 70% ethyl alcohol). I've ordered a UV-C lamp which I will try on my next round of plates.
I managed to isolate what looked like healthy mycelium from one plate and have been growing that out and even made what looks like a healthy LC from it, but because I've only managed to do this once, I am a bit worried that it may not even be pan myc, and so would prefer not to rest all my efforts on one success.
I've attached pictures of the specimens I made the prints from, some of the plates, and some of what I hope is healthy pan MYC. Any comments or tips welcome!
I've tried plain water agar, as I saw a video about using this as a way to get a small amount of mycelium to form without having bacteria overtake it too quickly, but that didn't work at all.
I've tried dropping spores on soaked and sterilized cardboard but nothing here either.
I'm using PDA for my plates. I sterilize everything with a pressure cooker and work in a still airbox trying to keep things as sterile as possible (which amounts to dousing everything with 70% ethyl alcohol). I've ordered a UV-C lamp which I will try on my next round of plates.
I managed to isolate what looked like healthy mycelium from one plate and have been growing that out and even made what looks like a healthy LC from it, but because I've only managed to do this once, I am a bit worried that it may not even be pan myc, and so would prefer not to rest all my efforts on one success.
I've attached pictures of the specimens I made the prints from, some of the plates, and some of what I hope is healthy pan MYC. Any comments or tips welcome!